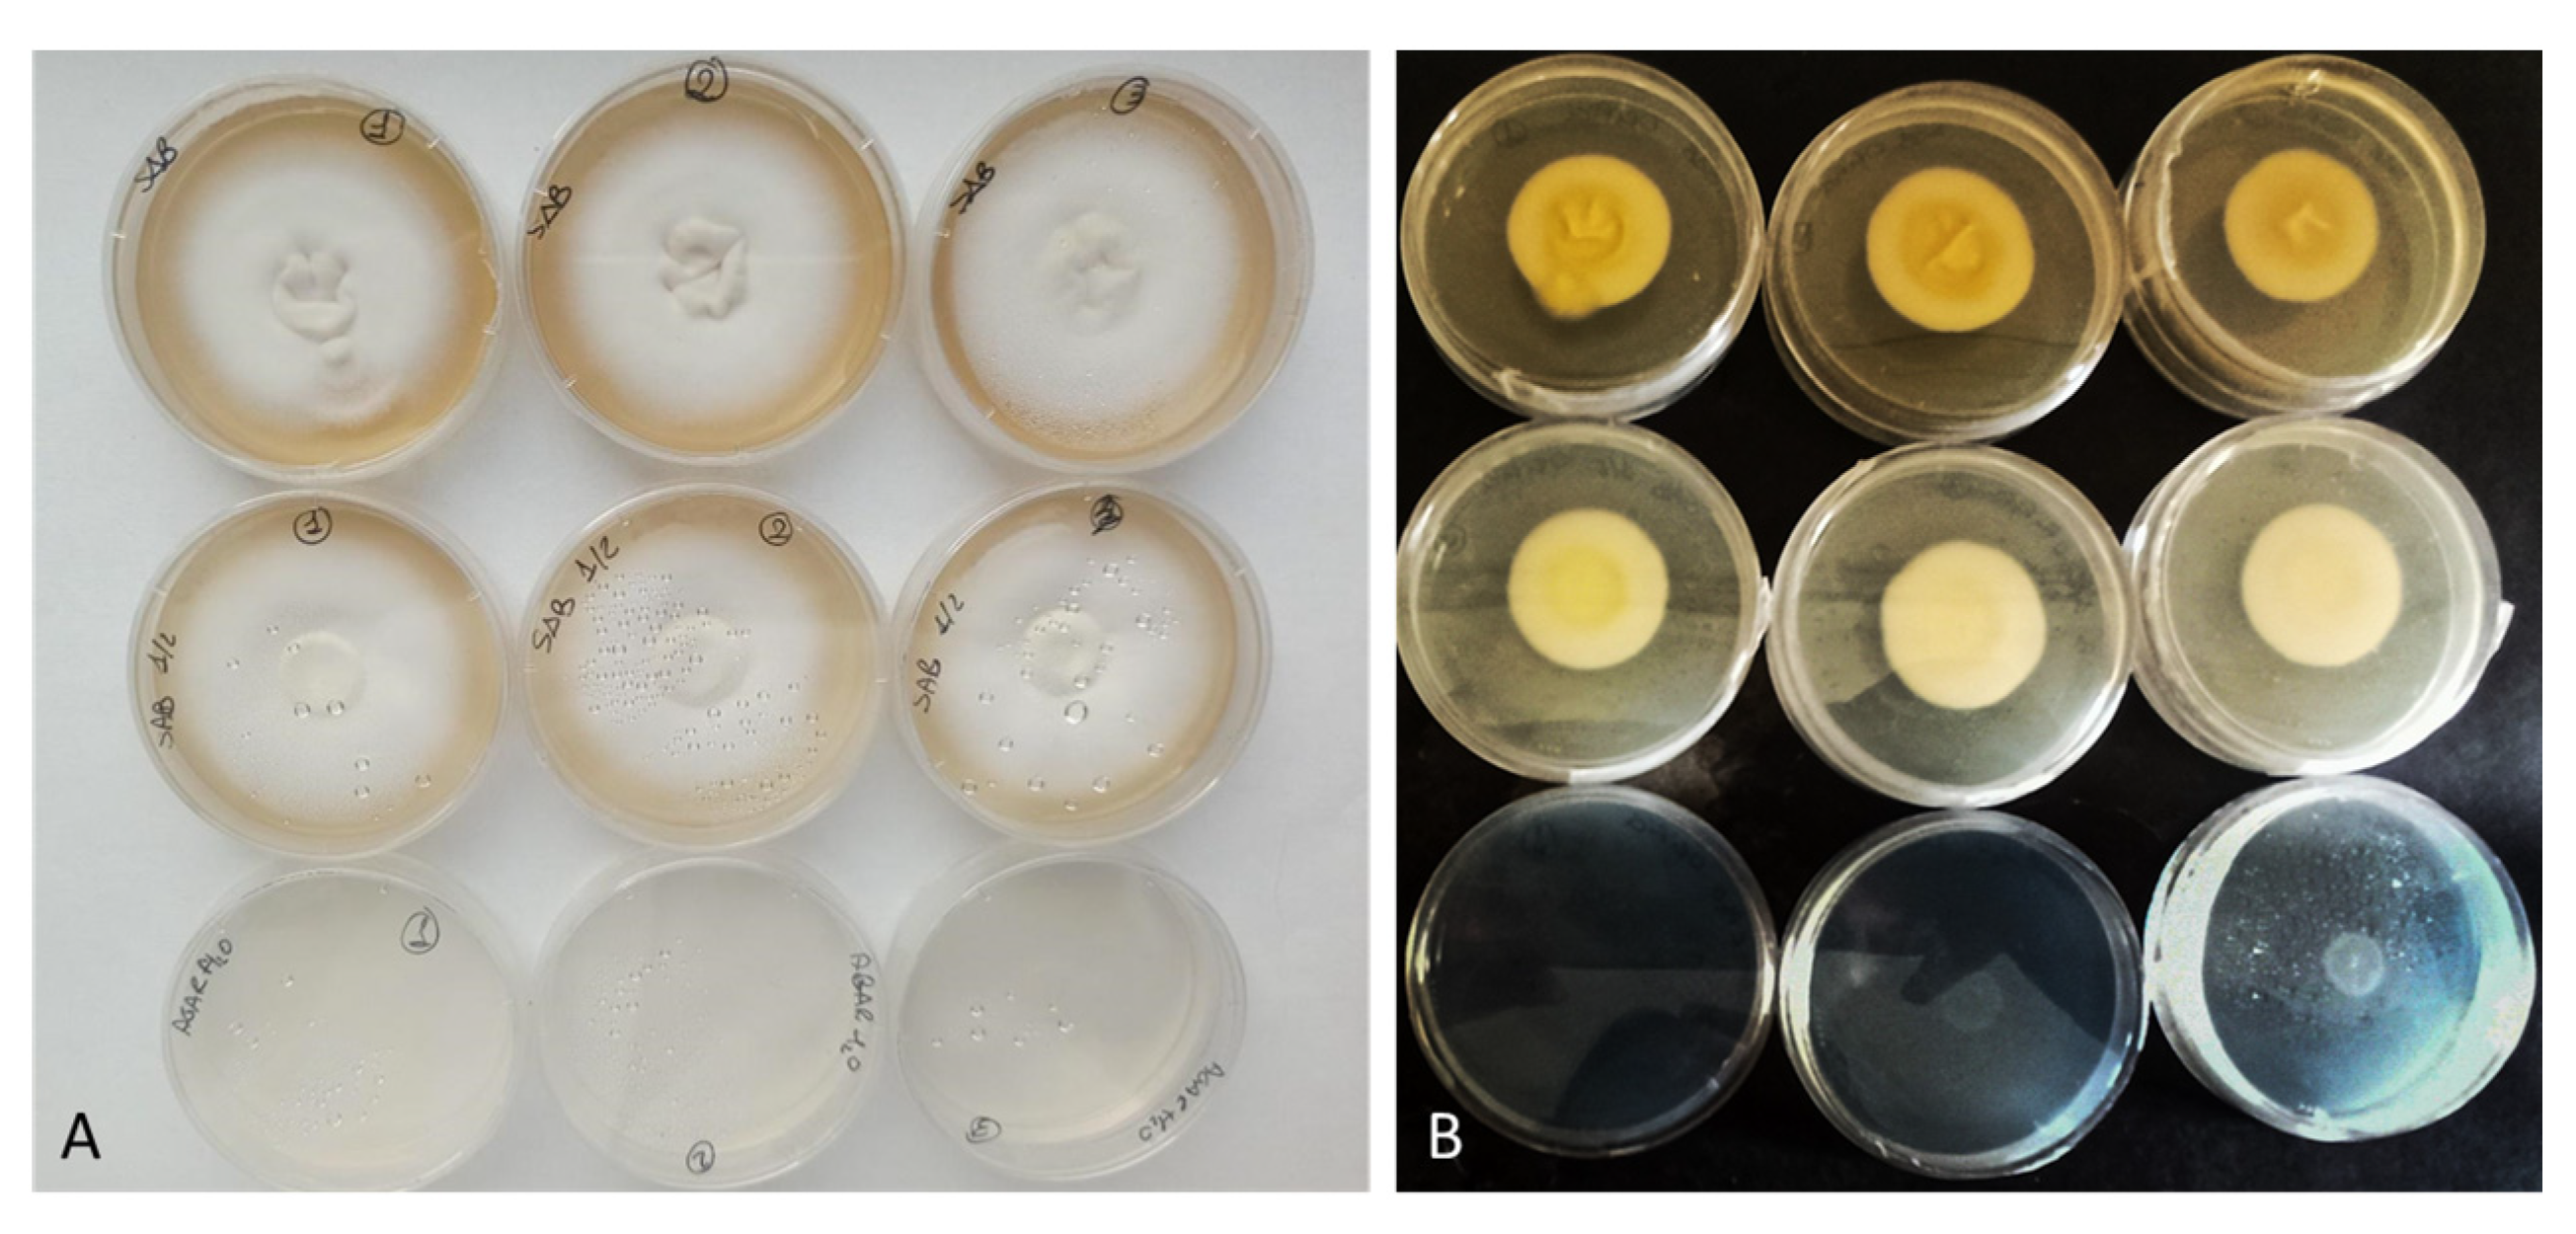
Jof 08 01133 g002 Jof 08 01133 g002

Efficacy of Bovine Nail Membranes as In Vitro Model for Onychomycosis Infected by Trichophyton Species
Abstract
1. Introduction
2. Materials and Methods
2.1. Collection of Nail Samples Affected by Onychomycosis
2.2. Isolation of Etiological Agents
2.3. Fungal Identification
2.4. Growth Tests
- Water Agar (WA) as a minimal medium: 15 g/L Agar;
- Sabouraud Dextrose Agar (SDA) as rich medium: 30 g/L Sabouraud Dextrose Broth + 15 g/L Agar;
- ½ SDA as an intermediate medium: 15 g/L of Sabouraud Dextrose Broth and 15 g/L Agar.
2.5. Bovine Membrane Production
2.6. Fungal Colonization of Bovine Membrane
2.7. Membrane Characterization
2.7.1. Contact Angle Measurement
2.7.2. Mechanical Properties Assessment
2.7.3. Scanning Electron Microscopy
2.8. Statistical Analysis
3. Results
3.1. Dermatophytes Isolation and Identification
3.2. Growth Tests
3.3. Membrane Colonisation
3.4. Membrane Characterization
3.4.1. Contact Angle Measurement
3.4.2. Mechanical Properties Assessment
3.4.3. SEM
4. Discussion
5. Conclusions
Author Contributions
Funding
Institutional Review Board Statement
Informed Consent Statement
Data Availability Statement
Acknowledgments
Conflicts of Interest
References
- Gupta, A.; Mays, R.; Versteeg, S.; Piraccini, B.; Takwale, A.; Shemer, A.; Babaev, M.; Grover, C.; Di Chiacchio, N.; Taborda, V.; et al. Global perspectives for the management of onychomycosis. Int. J. Dermatol. 2019, 58, 1118–1129. [Google Scholar] [CrossRef]
- Piraccini, B.M.; Alessandrini, A. Onychomycosis: A review. J. Fungi 2015, 1, 30–43. [Google Scholar] [CrossRef]
- Kaur, R.; Kashyap, B.; Bhalla, P. Onychomycosis–Epidemiology, diagnosis and management. Indian J. Med. Microbiol. 2008, 26, 108–116. [Google Scholar] [CrossRef]
- Leung, A.K.C.; Lam, J.M.; Leong, K.F.; Hon, K.L.; Barankin, B.; Leung, A.A.M.; Wong, A.H.C. Onychomycosis: An Updated Review. Recent Pat. Inflamm. Allergy Drug Discov. 2020, 14, 32–45. [Google Scholar] [PubMed]
- Gupta, A.; Versteeg, S.; Shear, N.; Piguet, V.; Tosti, A.; Piraccini, B. A pratical guide to curing onychomycosis: How to maximize cure at the patient, organism, treatment and environmental level. Am. J. Clin. Dermatol. 2019, 20, 123–133. [Google Scholar] [CrossRef]
- Queller, J.; Bhatia, N. The dermatologist’s approach to onychomycosis. J. Fungi 2015, 1, 173–184. [Google Scholar] [CrossRef]
- Moreno, G.; Arenas, R. Other fungi causing onychomycosis. Clin. Dermatol. 2010, 28, 160–163. [Google Scholar] [CrossRef] [PubMed]
- Faergemann, J.; Baran, R. Epidemiology, clinical presentation and diagnosis of onychomycosis. Br. J. Dermatol. 2003, 149, 1–4. [Google Scholar] [CrossRef]
- Papini, M.; Piraccini, B.M.; Difonzo, E.; Brunoro, A. Epidemiology of onychomycosis in Italy: Prevalence data and risk factor identification. Mycoses 2015, 58, 659–664. [Google Scholar] [CrossRef]
- Sergeev, A.Y.; Gupta, A.K.; Sergeev, Y.V. The scoring clinical index for onychomycosis (SCIO index). Ski. Ther. Lett 2002, 7 (Suppl. 1), 6–7. [Google Scholar]
- Sigurgeirsson, B.; Baran, R. The prevalence of onychomycosis in the global population–a literature study. J. Eur. Acad. Dermatol. Venereol. 2014, 28, 1480–1491. [Google Scholar] [CrossRef]
- Effendy, I.; Lecha, M.; Feuilhade de Chauvin, M.; Di Chiacchio, N.; Baran, R. Epidemiology and clinical classification of onychomycosis. J. Eur. Acad. Dermatol. Venereol. 2005, 19, 8–12. [Google Scholar] [CrossRef]
- Zhan, P.; Dukik, K.; Li, D.; Sun, J.; Stielow, J.B.; Gerrits van den Ende, B.; Brankovics, B.; Menken, S.B.J.; Mei, H.; Bao, W.; et al. Phylogeny of dermatophytes with genomic character evaluation of clinically distinct Trichophyton rubrum and T. violaceum. Stud. Mycol. 2018, 89, 153–175. [Google Scholar] [CrossRef]
- Frías-De-León, M.G.; Martínez-Herrera, E.; Atoche-Diéguez, C.E.; González-Cespón, J.L.; Uribe, B.; Arenas, R.; Rodríguez-Cerdeira, C. Molecular identification of isolates of the Trichophyton mentagrophytes complex. Int. J. Med. Sci. 2020, 17, 45. [Google Scholar] [CrossRef] [PubMed]
- Burstein, V.L.; Beccacece, I.; Guasconi, L.; Mena, C.J.; Cervi, L.; Chiapello, L.S. Skin immunity to dermatophytes: From experimental infection models to human disease. Front. Immunol. 2020, 11, 605644. [Google Scholar] [CrossRef] [PubMed]
- Lux, J.; Dobiáš, R.; Kuklová, I.; Litvik, R.; Scholtz, V.; Souškova, H.; Khun, J.; Mrázek, J.; Kantorová, M.; Jaworská, P.; et al. Inactivation of dermatophytes causing onychomycosis and its therapy using non-thermal plasma. J. Fungi 2020, 6, 214. [Google Scholar] [CrossRef]
- Mercer, D.K.; Stewart, C.S. Keratin hydrolysis by dermatophytes. Med. Mycol. J. 2019, 57, 13–22. [Google Scholar] [CrossRef] [PubMed]
- Mukesh, S.; Meenakshi, S.; Vijay, M.R. In vitro biodegradation of keratin by dermatophytes and some soil keratinophiles. Afr. J. Biomed. Res. 2011, 5, 1–6. [Google Scholar]
- Zhang, X.; Wang, Y.; Chi, W.; Shi, Y.; Chen, S.; Lin, D.; Jin, Y. Metalloprotease genes of Trichophyton mentagrophytes are important for pathogenicity. Med. Mycol. J. 2014, 52, 36–45. [Google Scholar]
- Kunert, J. Physiology of keratinophilic fungi. Rev. Iberoam. Micol. 2000, 1, 77–85. [Google Scholar]
- Tang, C.; Kong, X.; Ahmed, S.A.; Thakur, R.; Chowdhary, A.; Nenoff, P.; Uhrlass, S.; Verma, S.B.; Meis, J.F.; Kandemir, H.; et al. Taxonomy of the Trichophyton mentagrophytes/T. interdigitale species complex harboring the highly virulent, multiresistant genotype T. indotineae. Mycopathologia 2021, 186, 315–326. [Google Scholar] [CrossRef] [PubMed]
- Taghipour, S.; Pchelin, I.M.; Mahmoudabadi, A.Z.; Ansari, S.; Katiraee, F.; Rafiei, A.; Shokohi, T.; Abastabar, M.; Taraskina, A.E.; Kermani, F.; et al. Trichophyton mentagrophytes and T interdigitale genotypes are associated with geographic areas and clinical manifestations. Mycoses 2019, 62, 1084–1091. [Google Scholar] [CrossRef] [PubMed]
- Pchelin, I.M.; Azarov, D.V.; Churina, M.A.; Scherbak, S.G.; Apalko, S.V.; Vasilyeva, N.V.; Taraskina, A.E. Species boundaries in the Trichophyton mentagrophytes/T. interdigitale species complex. Med. Mycol. J. 2019, 57, 781–789. [Google Scholar] [CrossRef] [PubMed]
- White, T.; Findley, K.; Dawson, T.; Scheynius, A.; Boekhout, T.; Cuomo, C.; Xu, J.; Saunders, C. Fungi on the skin: Dermatophytes and Malassezia. Cold Spring Harb. Perspect. Med. 2014, 4, a019802. [Google Scholar] [CrossRef]
- Nenoff, P.; Herrmann, J.; Gräser, Y. Trichophyton mentagrophytes sive interdigitale? A dermatophyte in the course of time. J Dtsch. Dermatol. Ges. 2007, 5, 198–202. [Google Scholar] [CrossRef] [PubMed]
- Cordoba Díaz, D.; Losa Iglesias, M.E.; Becerro de Bengoa Vallejo, R.; Cordoba Diaz, M. Transungual Delivery of Ciclopirox Is Increased 3–4-Fold by Mechanical Fenestration of Human Nail Plate in an In Vitro Model. Pharmaceutics 2019, 11, 29. [Google Scholar] [CrossRef] [PubMed]
- Monti, D.; Mazzantini, D.; Tampucci, S.; Vecchione, A.; Celandroni, F.; Burgalassi, S.; Ghelardi, E. Ciclopirox and efinaconazole transungual permeation, antifungal activity, and proficiency to induce resistance in Trichophyton rubrum. Antimicrob. Agents Chemother. 2019, 63, e00442-19. [Google Scholar] [CrossRef] [PubMed]
- Nogueiras-Nieto, L.; Gómez-Amoza, J.L.; Delgado-Charro, M.B.; Otero-Espinar, F.J. Hydration and N-acetyl-l-cysteine alter the microstructure of human nail and bovine hoof: Implications for drug delivery. JCR 2011, 156, 337–344. [Google Scholar] [CrossRef] [PubMed]
- Bonetti, M.; Bracchi, M.; Musitelli, G.; Perugini, P. Production and characterization of bovine hoof membranes as standardized in vitro model for nail studies. Int. J. Pharm. 2021, 600, 120409. [Google Scholar] [CrossRef] [PubMed]
- Lawry, M.A.; Haneke, E.; Strobeck, K.; Martin, S.; Zimmer, B.; Romano, P.S. Methods for diagnosing onychomycosis: A comparative study and review of the literature. Arch. Dermatol. 2000, 136, 1112–1116. [Google Scholar] [CrossRef]
- de Hoog, G.S.; Guarro, J.; Gené, J.; Figueras, M.J. Atlas of Clinical Fungi, 2nd ed.; Centraalbureau voor Schimmelcultures (CBS): Utrecht, The Netherlands, 2005. [Google Scholar]
- Kane, J.; Summerbell, R.; Sigler, L.; Krajden, S.; Land, G. Laboratory Handbook of Dermatophytes, 9th ed.; Star: Belmont, CA, USA, 2002; pp. 131–192. [Google Scholar]
- Martin, K.J.; Rygiewicz, P.T. Fungal-specific PCR primers developed for analysis of the ITS region of environmental DNA extracts. BMC Microbiol. 2005, 5, 28. [Google Scholar] [CrossRef]
- Mycoban. Available online: www.mycobank.org (accessed on 14 September 2022).
- Khan, A.M.; Bhadauria, S.; Yadav, R. Effect of environmental factors on isolation, mycelial growth and sporulation of keratinophilic fungi. Asian J. Exp. Sci. 2009, 23, 307–312. [Google Scholar]
- Sharma, A.; Chandra, S.; Sharma, M. Difference in keratinase activity of dermatophytes at different environmental conditions is an attribute of adaptation to parasitism. Mycoses 2012, 55, 410–415. [Google Scholar] [CrossRef]
- Perugini, P.; Sacchi, S.; Musitelli, G. Nail StrainStress Meter NM 100: A novel in vivo method to characterize biomechanical properties of nails. Ski. Res. Technol. 2020, 26, 422–430. [Google Scholar] [CrossRef]
- Gregoriou, S.; Mpali, N.; Vrioni, G.; Hatzidimitriou, E.; Chryssou, S.E.; Rigopoulos, D. Epidemiology of onychomycosis in an academic nail unit in South Greece during a three-year period. Ski. Appendage Disord. 2020, 6, 102–107. [Google Scholar] [CrossRef] [PubMed]
- Youssef, A.B.; Kallel, A.; Azaiz, Z.; Jemel, S.; Bada, N.; Chouchen, A.; Belhadj-Salah, N.; Fakhfakh, N.; Belhadj, S.; Kallel, K. Onychomycosis: Which fungal species are involved? Experience of the Laboratory of Parasitology-Mycology of the Rabta Hospital of Tunis. J. Mycol. Med. 2018, 28, 651–654. [Google Scholar] [CrossRef] [PubMed]
- Gupta, A.K.; Jain, H.C.; Lynde, C.W.; MacDonald, P.; Cooper, E.A.; Summerbell, R.C. Prevalence and epidemiology of onychomycosis in patients visiting physicians’ offices: A multicenter Canadian survey of 15,000 patients. JAAD 2000, 43, 244–248. [Google Scholar] [CrossRef]
- Kayarkatte, M.N.; Singal, A.; Pandhi, D.; Das, S. Clinico-mycological study of onychomycosis in a tertiary care hospital—A cross-sectional study. Mycoses 2020, 63, 113–118. [Google Scholar] [CrossRef] [PubMed]
- Hoy, N.Y.; Leung, A.K.; Metelitsa, A.I.; Adams, S. New concepts in median nail dystrophy, onychomycosis, and hand, foot, and mouth disease nail pathology. Int. Sch. Res. Not. 2012, 2012, 680163. [Google Scholar] [CrossRef]
- Kyriakou, A.; Zagalioti, S.C.; Trakatelli, M.G.; Fotiadou, C.; Apalla, Z.; Lazaridou, E.; Patsatsi, A. Fungal Infections and Nail Psoriasis: An Update. J. Fungi 2022, 8, 154. [Google Scholar] [CrossRef] [PubMed]
- Aragón-Sánchez, J.; López-Valverde, M.E.; Víquez-Molina, G.; Milagro-Beamonte, A.; Torres-Sopena, L. Onychomycosis and tinea pedis in the feet of patients with diabetes. Int. J. Low. Extrem. Wounds 2021, 15347346211009409. [Google Scholar] [CrossRef]
- Bitencourt, T.A.; Macedo, C.; Franco, M.E.; Rocha, M.C.; Moreli, I.S.; Cantelli, B.A.M.; Sanches, P.R.; Beleboni, R.O.; Malavazi, I.; Passos, G.A.; et al. Trans-chalcone activity against Trichophyton rubrum relies on an interplay between signaling pathways related to cell wall integrity and fatty acid metabolism. BMC Genom. 2019, 20, 411. [Google Scholar] [CrossRef] [PubMed]
- Sánchez, M.J.I.; Pico, A.M.P.; Tejedor, F.M.; Sánchez, M.J.I.; Acevedo, R.M. Using a polymerase chain reaction as a complementary test to improve the detection of dermatophyte fungus in nails. J. Am. Podiatr. Med. Assoc. 2014, 104, 233–237. [Google Scholar] [CrossRef]
- Tchernev, G.; Penev, P.K.; Nenoff, P.; Zisova, L.G.; Cardoso, J.C.; Taneva, T.; Ginter-Hanselmayer, G.; Ananiev, J.; Gulubova, M.; Hristova, R.; et al. Onychomycosis: Modern diagnostic and treatment approaches. Wien. Med. Wochenschr. 2013, 163, 1–12. [Google Scholar] [CrossRef]
- Lipner, S.R.; Scher, R.K. Onychomycosis: Clinical overview and diagnosis. J. Am. Acad. Dermatol. 2019, 80, 835–851. [Google Scholar] [CrossRef]
- Zisova, L.; Valtchev, V.; Sotiriou, E.; Gospodinov, D.; Mateev, G. Onychomycosis in patients with psoriasis—a multicentre study. Mycoses 2012, 55, 143–147. [Google Scholar] [CrossRef] [PubMed]
- Nematollahi, A.R.; Badiee, P.; Nournia, E. The efficacy of ultraviolet irradiation on Trichophyton species isolated from nails. Jundishapur. J. Microbiol. 2015, 8. [Google Scholar] [CrossRef] [PubMed]
- Gnat, S.; Łagowski, D.; Nowakiewicz, A.; Osińska, M.; Kopiński, Ł. Population differentiation, antifungal susceptibility, and host range of Trichophyton mentagrophytes isolates causing recalcitrant infections in humans and animals. Eur. J. Clin. Microbiol. Infect. Dis. 2020, 39, 2099–2113. [Google Scholar] [CrossRef] [PubMed]
- Hubka, V.; Cmokova, A.; Skorepova, M.; Mikula, P.; Kolarik, M. Trichophyton onychocola sp. nov. isolated from human nail. Med. Mycol. J. 2014, 52, 285–292. [Google Scholar] [CrossRef] [PubMed]
- Valkov, A.; Zinigrad, M.; Sobolev, A.; Nisnevitch, M. Keratin biomembranes as a model for studying onychomycosis. Int. J. Mol. Sci. 2020, 21, 3512. [Google Scholar] [CrossRef] [PubMed]
- Reichl, S.; Müller-Goymann, C.C. Infected nail plate model made of human hair keratin for evaluating the efficacy of different topical antifungal formulations against Trichophyton rubrum in vitro. Eur. J. Pharm. Biopharm. 2013, 84, 599–605. [Google Scholar]
- Laroche, L.; Bourgeois, N.; Lachaud, L.; Rispail, P. Epidemiological analysis of nail aspergillosis and non-dermatophyte moulds. Criteria for the involvement of Aspergillus in 102 cases of onychomycosis at Montpellier University Hospital, France (1991–2019). Mycoses 2021, 64, 1546–1553. [Google Scholar] [CrossRef] [PubMed]
- Zafindraibe, N.J.; Tsatoromila, F.A.M.; Rakotoarivelo, Z.H.; Rakotozandrindrainy, N.; Rafalimanana, C.; Rakoto-Alson, O.A.; Razanakolona, L.R.S. Onychomycosis: Experience of the laboratory of parasitology-mycology of CHU-Joseph Ravoahangy Andrianavalona, Antananarivo, Madagascar. PAMJ 2021, 40, 176. [Google Scholar] [CrossRef] [PubMed]
- Rashid, A.; Scott, E.; Richardson, M.D. Early events in the invasion of the human nail plate by Trichophyton mentagrophytes. Br. J. Dermatol. 1995, 133, 932–940. [Google Scholar] [CrossRef] [PubMed]
- Martinez-Rossi, N.M.; Peres, N.T.; Rossi, A. Pathogenesis of dermatophytosis: Sensing the host tissue. Mycopathologia 2017, 182, 215–227. [Google Scholar] [CrossRef] [PubMed]
- Perugini, P.; Bonetti, M.; Guerini, M.; Musitelli, G.; Grisoli, P. A New In Vitro Model to Evaluate Anti-Adhesive Effect against Fungal Nail Infections. Appl. Sci. 2021, 11, 1977. [Google Scholar] [CrossRef]
- Kappes, S.; Faber, T.; Nelleßen, L.; Yesilkaya, T.; Bock, U.; Lamprecht, A. Improving Transungual Permeation Study Design by Increased Bovine Hoof Membrane Thickness and Subsequent Infection. Pharmaceutics 2021, 13, 2098. [Google Scholar] [CrossRef] [PubMed]

| Start Position | 2.3 mm |
|---|---|
| Step Size | 0.001 mm |
| Start Force | 0.10 N |
| Stop Force | 6 N |
| Deflection | 10 mm |
| Code | Species |
|---|---|
| 1000A | T. rubrum |
| 1000B | T. rubrum |
| 10318 | T. rubrum |
| 10351 | T. rubrum |
| 10356 | T. rubrum |
| 10380 | T. rubrum |
| 10379 | T. interdigitale |
| 10326 | T. mentagrophytes |
| 10340 | T. mentagrophytes |
Publisher’s Note: MDPI stays neutral with regard to jurisdictional claims in published maps and institutional affiliations. |
© 2022 by the authors. Licensee MDPI, Basel, Switzerland. This article is an open access article distributed under the terms and conditions of the Creative Commons Attribution (CC BY) license (https://creativecommons.org/licenses/by/4.0/).
Share and Cite
Temporiti, M.E.E.; Guerini, M.; Baiguera, R.M.; Buratti, S.; Desiderio, A.; Goppa, L.; Perugini, P.; Savino, E. Efficacy of Bovine Nail Membranes as In Vitro Model for Onychomycosis Infected by Trichophyton Species. J. Fungi 2022, 8, 1133. https://doi.org/10.3390/jof8111133
Temporiti MEE, Guerini M, Baiguera RM, Buratti S, Desiderio A, Goppa L, Perugini P, Savino E. Efficacy of Bovine Nail Membranes as In Vitro Model for Onychomycosis Infected by Trichophyton Species. Journal of Fungi. 2022; 8(11):1133. https://doi.org/10.3390/jof8111133
Chicago/Turabian StyleTemporiti, Marta Elisabetta Eleonora, Marta Guerini, Rebecca Michela Baiguera, Simone Buratti, Anthea Desiderio, Lorenzo Goppa, Paola Perugini, and Elena Savino. 2022. "Efficacy of Bovine Nail Membranes as In Vitro Model for Onychomycosis Infected by Trichophyton Species" Journal of Fungi 8, no. 11: 1133. https://doi.org/10.3390/jof8111133
APA StyleTemporiti, M. E. E., Guerini, M., Baiguera, R. M., Buratti, S., Desiderio, A., Goppa, L., Perugini, P., & Savino, E. (2022). Efficacy of Bovine Nail Membranes as In Vitro Model for Onychomycosis Infected by Trichophyton Species. Journal of Fungi, 8(11), 1133. https://doi.org/10.3390/jof8111133

